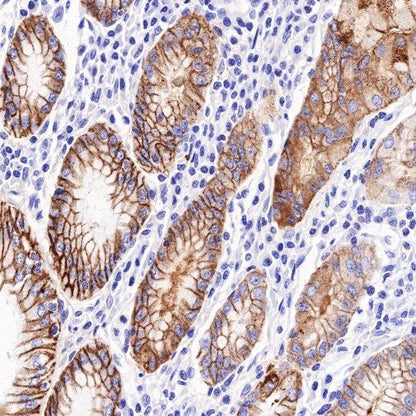

IHC shows positive staining in paraffin-embedded human stomach. Anti-Claudin18.2 (S0B2069) antibody was used at 1/500 dilution (prepared with S0D0001), followed by a HRP Polymer for Mouse & Rabbit IgG (ready to use). Counterstained with hematoxylin. Heat mediated antigen retrieval with Tris/EDTA buffer pH9.0 was performed before commencing with IHC staining protocol.
Product Details
Product Details
Product Specification
Stability & Storage | 3 months from date of receipt / reconstitution, 4 °C as supplied |
Background
This antibody Diluent is supplied as a working solution. It is for use in immunohistochemical assays. This diluent can improve IHC signal and background but not compatible with all antibody products.
Picture
Picture
Immunohistochemistry


Negative control: IHC shows negative staining in paraffin-embedded human skeletal muscle. Anti-Claudin18.2 (S0B2069) antibody was used at 1/500 dilution (prepared with S0D0001), followed by a HRP Polymer for Mouse & Rabbit IgG (ready to use). Counterstained with hematoxylin. Heat mediated antigen retrieval with Tris/EDTA buffer pH9.0 was performed before commencing with IHC staining protocol.